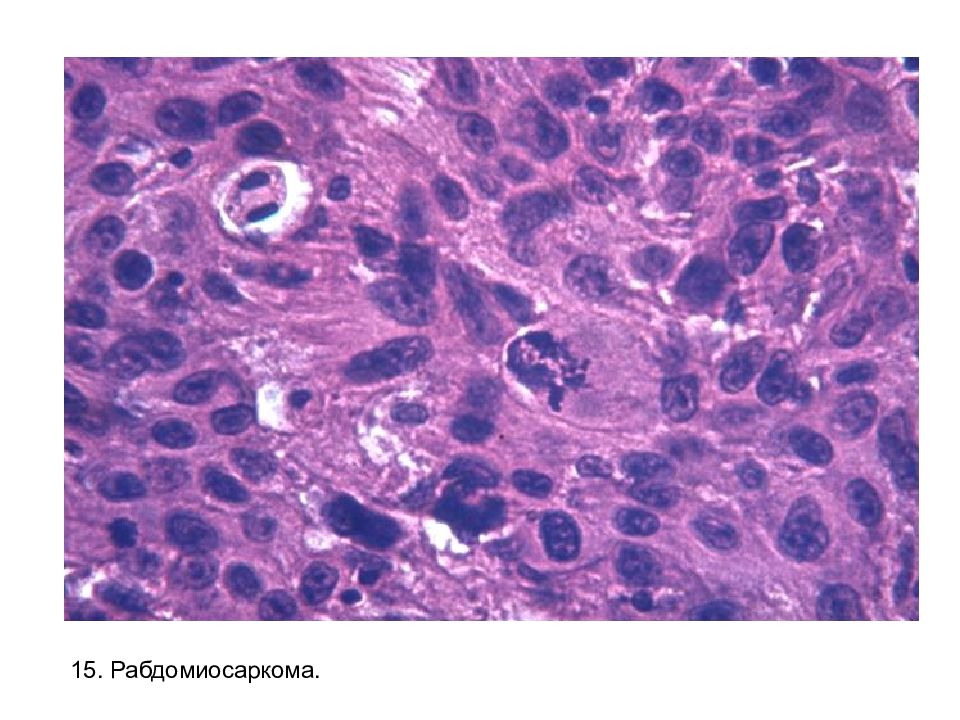

Первый слайд презентации
1. Печень при хроническом венозном полнокровии. Синусоиды в центрах долек расширены, заполнены эритроцитами. Печеночные балки в центрах долек атрофичны, истончены.
Слайд 2
2. Тромб в вене скелетной мышцы. Наличие в пристеночной зоне ядер фибробластов свидетельствует о начальных явлениях организации.
Слайд 4
4. Казеозная пневмония. В альвеолах рядом с очагом казеозного некроза фибрин и нейтрофильные лейкоциты.
Слайд 5
5. Инфаркт почки (слева). Видны только контуры структур в виде клеток-теней. Справа для сравнения – сохранившаяся ткань.
Слайд 6
6. Амилоидоз почки. Амилоид в клубочке. Слева – окраска конго-рот, справа – генцианвиолет.
Слайд 8
1 2 7. Печень при малярии. В звездчатых ретикулоэндотелиоцитах (1) (клетках Купфера) черный пигмент - гемомеланин и гемосидерин (не виден), в гепатоцитах – гемосидерин (2).
Слайд 9
8. Печень при обтурационной желтухе. Видна желчь в желчных проточках (имеющих свою эпителиальную выстилку.
Слайд 11
9. Крупозный бронхит. 1 – фибрин с нейтрофильными лейкоцитами, 2 – собственная пластинка слизистой без эпителия, инфильтрированная лейкоцитами, 3 – хрящ. 1 2 3
Слайд 12
10. Дифтеритический колит. 1 – фибрин с нейтрофильными лейкоцитами, 2 – собственная пластинка слизистой без эпителия, инфильтрированная нейтрофильными лейкоцитами. 1 2
Слайд 13
1 2 3 4 11. Милиарные туберкулезные бугорки в легком. 1 – эпителиоидные клетки, 2 – лимфоциты, 3 – гигантская многоядерная клетка Пирогова-Лангганса, 4 – очаг казеозного некроза в центре бугорка.
Слайд 15
12. Почка с метастатическими гнойными очагами при сепсисе. 1 – микроабсцесс, 2 – колония стафилококков в просвете мелкой артерии.
Слайд 16
13.Инфаркт миокарда. Кардиомиоциты без ядер, между ними – нейтрофильные лейкоциты (демаркационное воспаление).
Слайд 17
14. Почка при гипертонической болезни. 1 - гиалинизированный клубочек, 2 – мелкая артерия с гиалинозом. 1 2
Слайд 19
16. Аденокарцинома желудка. Атипичные эпителиальные клетки формируют атипичные железы.
Слайд 20
17. Печень при хроническом лимфолейкозе. Опухолевый инфильтрат имеет четкие очертания.
Слайд 22
18. Групповой фолликул при брюшном тифе. Вместо лимфоцитов в фолликуле макрофаги - «светлые брюшнотифозные клетки».
Слайд 23
19. Массивный некроз печени при вирусном гепатите В (молниеносной форме).
Слайд 24
20. Печень при циррозе. Окраска по Ван- Гизону на коллаген. Разрастания соединительной ткани формируют ложные дольки, не имеющие в середине центральной вены (стрелки)
Слайд 26
22. Гнойный менингит. ( Leptomeninx (греч.) – мягкая мозговая оболочка).
Слайд 27
23.Стафилококковые гнойники в легких при сепсисе. Гнойник – не на фоне пневмонии. Колонии стафилококков имеют вид «чернильных пятен».
Слайд 28
24. Крупозная пневмония, стадия серого опеченения. Экссудат в альвеолах состоит из фибрина и нейтрофильных лейкоцитов.
Слайд 29
25. Флегмонозно-язвенный аппендицит. Мышечная оболочка (1) и другие густо инфильтрированы нейтрофильными лейкоцитами, слизистая оболочка субтотально разрушена. 1
Слайд 30
26. Хроническая язва желудка. Дно язвы представлено рубцовой тканью (1) и грануляционной (2) с лейкоцитарно-некротическим слоем (3). 2 1 3 3 2
Слайд 31
27. Возвратный бородавчатый эндокардит створки клапана сердца. 1 – створка, 2 – тромботические массы. 2 1
Слайд 32
27. Возвратный бородавчатый эндокардит створки клапана сердца. Очаги фибриноидного набухания в створке (стрелки).
Слайд 33
28. Почка при быстропрогрессирующем гломерулонефрите. Полулуния из макрофагов (стрелка).
Слайд 34
29. Легкое при огнестрельном пулевом ранении. Раневой канал (1) и массивное кровоизлияние (2) за счет бокового удара пули. 1 2